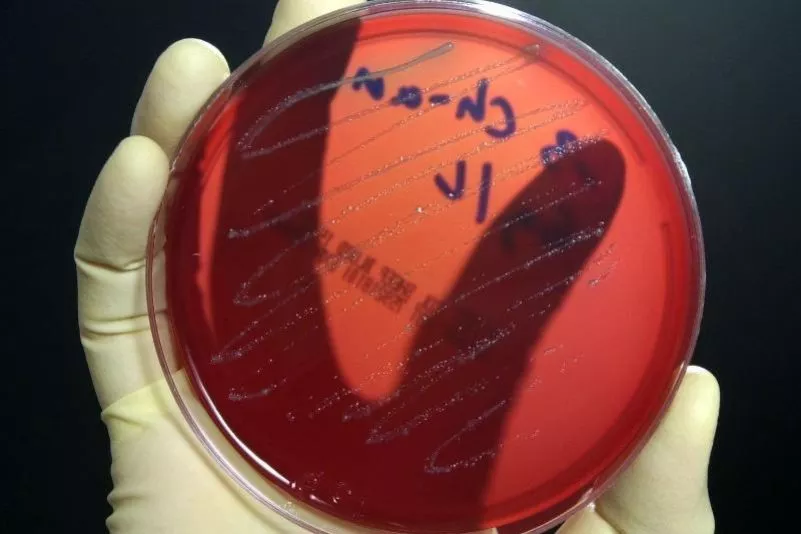
top-article-image

Jetlag bringt auch Darmbakterien aus dem Takt
Rehovot (dpa) – Auch Darmbakterien leben nach einer inneren Uhr. Gerät sie infolge von Schichtarbeit oder eines Jetlags aus dem Takt, kann das beim Menschen womöglich Übergewicht und Stoffwechsel-Erkrankungen zur Folge haben. Das berichten…
Petrischale mit Darmbakterien.
Foto: Ralf Hirschberger/Archiv/dpa
Rehovot (dpa) – Auch Darmbakterien leben nach einer inneren Uhr. Gerät sie infolge von Schichtarbeit oder eines Jetlags aus dem Takt, kann das beim Menschen womöglich Übergewicht und Stoffwechsel-Erkrankungen zur Folge haben.
Das berichten israelische Wissenschaftler im Fachmagazin „Cell“. Ihre Erkenntnisse könnten dazu beitragen, Mittel zur Prävention oder Behandlung dieser Krankheiten zu entwickeln.
Die innere Uhr des Menschen wird durch den Tag-Nacht-Rhythmus gesteuert, genauer gesagt durch den Wechsel von Licht und Dunkelheit. Es ist bekannt, dass Störungen, wie sie etwa bei Schichtarbeitern vorkommen oder bei Menschen, die häufig von einer Zeitzone in andere fliegen, Herzkreislauf-Erkrankungen, Diabetes oder Übergewicht verursachen können. Warum das so ist, wissen Fachleute nicht genau.
Die Forscher um Christoph Thaiss vom Weizmann Institute of Science in Rehovot prüften nun, ob die Darmflora damit etwas zu tun haben könnte. Sie ist nicht an der Verdauung beteiligt, sondern beeinflusst auch unsere Gesundheit erheblich. Aktuelle Untersuchungen legen zum Beispiel nahe, dass sie an der Entstehung von Asthma, Allergien, Übergewicht oder Diabetes beteiligt sein könnte.
Die Wissenschaftler untersuchten, wie sich die Zusammensetzung der Bakterien im Laufe des Tages ändert – zunächst bei Mäusen. Sie fanden, dass die Häufigkeit verschiedener Arten von Bakterien im Verlauf des Tages zu- und abnimmt. Auch spezifische Funktionen der Darmflora veränderten sich rhythmisch. Bei den nachtaktiven Nagern dominierten in der Dunkelphase etwa Stoffwechselwege, die mit dem Energiehaushalt, der Nahrungsverwertung oder dem Wachstum in Verbindung stehen. In der hellen Phase stand unter anderem die Entgiftung im Vordergrund.
Getaktet werde die innere Uhr der Bakterien auch über den Zeitpunkt der Nahrungsaufnahme, berichten die Wissenschaftler. Veränderten die Forscher die Fütterungszeiten der Mäuse und den Hell-Dunkel-Wechsel, geriet die Darmflora durcheinander. Eine fetthaltige Ernährung führte unter diesen Bedingungen zu Übergewicht und Glukoseintoleranz, die als Vorstufe von Diabetes gilt. Bei den normal getakteten Mäusen geschah das nicht.
Übertrugen die Wissenschaftler die Darmflora von „Jetlag-Mäusen“ auf keimfreie Mäuse, legten diese ebenfalls an Gewicht und Körperfett zu. Auch ihr Blutzuckerspiegel stieg. Die Darmflora von Kontrolltieren bewirkte dies wiederum nicht.
Anschließend zeigten Thaiss und seine Mitarbeiter, dass auch die Darmflora des Menschen rhythmischen Schwankungen unterliegt und ein Jetlag ebenfalls die Zusammensetzung der Bakterien verändert. Mäuse, die Bakterien aus dem Darm solcher Probanden erhielten, nahmen zu und ihr Blutzuckerspiegel stieg.
Ihre Ergebnisse seien als vorläufig zu betrachten, schreiben die Wissenschaftler. Sie legten jedoch nahe, dass Störungen der inneren Uhr beim Menschen die mikrobielle Gemeinschaft im Darm veränderten, was wiederum Stoffwechsel-Probleme möglich mache. Dies könne die Verbindung zwischen Schichtarbeit, häufigen Flugreisen und Erkrankungen erklären. Zur Behandlung biete sich möglicherweise eine gezielt probiotische oder antimikrobielle Therapie an, schreiben die Forscher.
„Dass sich die Darmflora in Abhängigkeit vom Zeitpunkt der Nahrungsaufnahme ändert, ist für mich als Mikrobiologen erst mal nicht so erstaunlich“, sagte Michael Blaut, Leiter der Abteilung Gastrointestinale Mikrobiologie am Deutschen Institut für Ernährungsforschung (DIfE) in Potsdam. Allerdings komme die Studie zu interessanten Ergebnissen. Sie liefere überzeugende Argumente dafür, dass ein Organismus auch in seiner Mikroflora abgebildet werde. Blaut betonte, dass Veränderungen der Darmflora wie die nach einem Jetlag innerhalb kurzer Zeit umkehrbar seien.
Eine Forschergruppe um Blaut hatte kürzlich gezeigt, dass das im menschlichen Darm vorkommende Bakterium Clostridium ramosum Übergewicht fördert. Es begünstigt scheinbar die Zucker- und Fettaufnahme aus dem Dünndarm.
Kommentare
Noch keine Kommentare – schreiben Sie den ersten Kommentar zu diesem Artikel.
0
Kommentare
Noch keine Kommentare – schreiben Sie den ersten Kommentar zu diesem Artikel.





